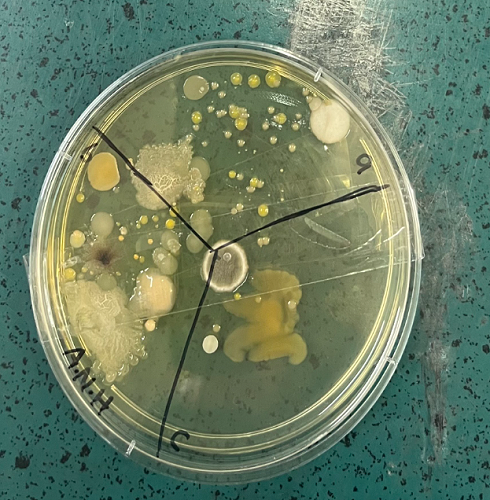
Foe: Petri dish showing fungus, yeast and bacteria present on hand railings, outside tables and door handles.

Putting the Fun in Fungus!
By Jess Lach | Posted: Wednesday August 20, 2025
Year 10 Science have been working on the Friend or Foe unit where students have been investigating whether certain types of fungus and bacteria are harmful or helpful to us humans. Part of our investigation included taking swabs of different parts of the school and culturing them on nutrient agar in the incubator. We were shocked to discover that microbes are very present in areas where we frequently place our hands and food! It gives us a reminder that we should always wash our hands before eating to avoid culturing harmful microorganisms in our own bodies.
However we have also found fun in our spore-producing friends as we cultivated our own oyster mushrooms and had a mini feast after sauteeing them in butter with a little salt and pepper. Special thanks to Mrs Lewis who allowed us to cook our fungus in the food tech classroom.